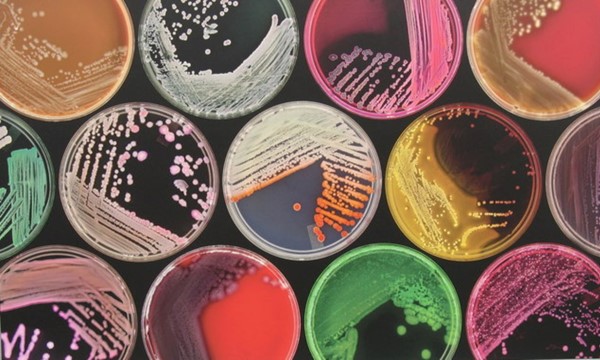

Microbiology Ubiquity Experiment Event - Reviewing Our Results!
Microbiology Ubiquity Experiment Event - Reviewing Our Results! Join us again as a continuation from our ubiquity lab experiment! This time, we’ll be following up on the famous Microbiology Ubiquity experiment by viewing the exciting results. You’ll have the chance to observe the bacteria we collected from campus surfaces and examine them under the microscope. Not only will you see firsthand the incredible diversity of microorganisms in our environment, but you’ll also gain experience with microbiological observation techniques. These results will also be added to our Microbiome Portal project, expanding our research and data collection. Don’t miss this unique opportunity to explore the unseen world of microbes and connect with fellow AMSA members. We can’t wait to see you there! From
to
at CB107.
Latest PBSC Engage!
- Observed Veteran's DayObserved Veteran's Day Please come take a brief, respectful pause to honor all who have served. From to at Belle Glade Campus.
- Parent Night SessionsParent Night Sessions The Parent Information Session provides an overview of Palm Beach State College and the opportunity to meet with College representatives to answer questions about the admissions process. You are welcome to register for a session if you are a parent of a new or prospective PBSC student. Session topics will include: Admissions Process Degrees & Certificates Short-Term Program Opportunities Financial Aid College Resources ---------------------------------------------------- ---------------------------------------------------- Click HERE to RSVP From to at Online.
- Parent Night SessionsParent Night Sessions The Parent Information Session provides an overview of Palm Beach State College and the opportunity to meet with College representatives to answer questions about the admissions process. You are welcome to register for a session if you are a parent of a new or prospective PBSC student. Session topics will include: Admissions Process Degrees & Certificates Short-Term Program Opportunities Financial Aid College Resources ---------------------------------------------------- ---------------------------------------------------- Click HERE to RSVP From to at Online.
- General Assembly MeetingGeneral Assembly Meeting The General Assembly Meeting serves as the central gathering of the Business Leadership Club, open to all members. These meetings provide an opportunity for students to connect, collaborate, and engage in leadership development while staying updated on club activities. Purpose: Share important updates from the Executive Board Introduce upcoming events, workshops, and initiatives Provide a platform for members to voice ideas, suggestions, and feedback Foster networking and collaboration among members Highlight opportunities to earn points toward membership recognition Format: Welcome & Announcements: Led by the President or Executive Board Club Updates: Upcoming events, projects, and opportunities Spotlight Activity: May include a mini-workshop, leadership exercise, or peer discussion Open Floor: Members are encouraged to share goals, challenges, or resources Closing & Reminders: Key takeaways and next steps Frequency:Held biweekly on Mondays at 6:00 PM, alternating between in-person and virtual formats (Teams), unless otherwise announced. Who Should Attend:All current and prospective members of the Business Leadership Club. From to at TBD.
- General Assembly MeetingGeneral Assembly Meeting The General Assembly Meeting serves as the central gathering of the Business Leadership Club, open to all members. These meetings provide an opportunity for students to connect, collaborate, and engage in leadership development while staying updated on club activities. Purpose: Share important updates from the Executive Board Introduce upcoming events, workshops, and initiatives Provide a platform for members to voice ideas, suggestions, and feedback Foster networking and collaboration among members Highlight opportunities to earn points toward membership recognition Format: Welcome & Announcements: Led by the President or Executive Board Club Updates: Upcoming events, projects, and opportunities Spotlight Activity: May include a mini-workshop, leadership exercise, or peer discussion Open Floor: Members are encouraged to share goals, challenges, or resources Closing & Reminders: Key takeaways and next steps Frequency:Held biweekly on Mondays at 6:00 PM, alternating between in-person and virtual formats (Teams), unless otherwise announced. Who Should Attend:All current and prospective members of the Business Leadership Club. From to at TBD.
- Zoom Bible StudyZoom Bible Study Join us as we fellowship through studying the Word together! Everyone is welcomed! Invite a friend or 10! Join Zoom Meeting https://us06web.zoom.us/j/9286378427?pwd=GpNqQZd2dqHk8nPfUaRtZdK2eCCrkY.1&omn=86840994685 Meeting ID: 928 637 8427 Passcode: Jesus From to at Online.